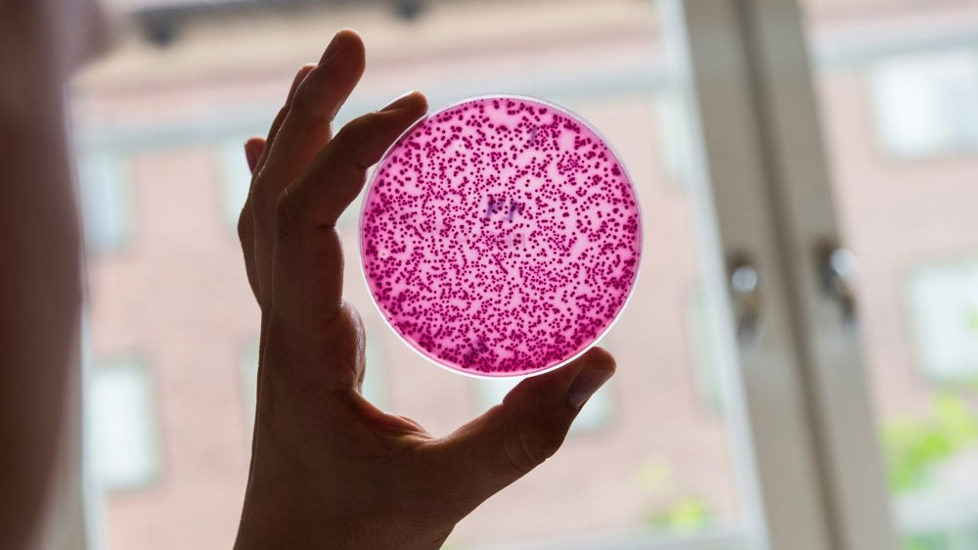

Antibiotikaresistens
Antibiotikaresistens - "The silent pandemic" er et raskt voksende problem i verden og utgjør en alvorlig trussel mot global helse. Når bakterier blir resistente mot antibiotika mister medisinen effekt, og det blir vanskeligere å behandle sykdommer. Vi risikerer en fremtid uten effektive antibiotika, der infeksjoner som i dag regnes som ufarlige igjen kan få dødelige utfall. Ifølge Verdens helseorganisasjon dør årlig minst 700 000 mennesker av resistente bakterier. Et høyt forbruk av antibiotika øker forekomsten av resistente bakterier. Derfor arbeider regjeringen for å redusere antibiotikabruken hos mennesker og dyr.

Om antibiotikabruk i norsk landbruk
Norge utmerker seg blant landene som bruker minst antibiotika i husdyrproduksjonen. Undersøkelser viser også at forekomsten av antibiotikaresistente bakterier i norsk mat og i norsk husdyrhold også er lav.
Norge tar en global lederrolle
Regjeringen har satt tydelige mål for å redusere bruken av antibiotika, og Norge er en pådriver i arbeidet med å kutte antibiotikabruken globalt.

Lav bruk av antibiotika i norske husdyrhold
Det er fortsatt lav bruk av antibiotika på norske landdyr, og bruken i norske husdyrhold har gått ytterligere ned i 2023. Dette viser resultatene i den årlige statusrapporten for forbruk av antibiotika til mennesker og dyr (NORM-VET rapporten).

Antibiotikaresistens er et lite problem i Norge
Hvert år tar Mattilsynet flere tusen prøver av mat, dyr, fisk, omgivelser, vann og fôr. En av de tingene Mattilsynet leter etter er antibiotikaresistente bakterier. Årets oppsummering viser få funn i Norge, men problemet vokser internasjonalt.